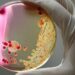

Scientists at Tohoku University in Japan have made a significant discovery in the field of cancer treatment. They have found a new approach to enhance the efficacy of immune checkpoint blockade (ICB), a type of cancer therapy that uses immune checkpoint inhibitors (ICIs), while also reducing the associated side effects. Their findings highlight the potential of utilizing ICIs to target tumor-positive lymph nodes, resulting in a potent anti-tumor response against both local and systemic metastases.
The immune system employs “checkpoint proteins” to regulate the activity of immune cells. However, cancer cells can exploit these checkpoints to evade detection by the immune system. ICB is an immunotherapy that aims to block these checkpoints, thereby empowering the immune system to combat cancer naturally, without directly attacking the cancer cells themselves. Nevertheless, the effectiveness of ICB can vary from person to person, and it can also lead to serious side effects known as immune-related adverse events (irAEs).
To improve the anti-tumor response while minimizing irAEs, the researchers hypothesized that targeting tumor-positive lymph nodes with ICB could be a promising approach. To test this hypothesis, they conducted experiments using anti-CTLA4, a commonly used ICI, on laboratory mice with lymph nodes and distant metastases. The results confirmed that directly administering CTLA4 blockers to tumor-positive lymph nodes resulted in a strong anti-tumor response against local and systemic metastases, leading to increased survival rates in the mice.
The anti-cancer effect observed was attributed to an increase in the functional T cell population within the tumor-positive lymph nodes and spleen. Non-specific CTLA4 blockades showed a diminished anti-tumor effect and worsened side effects, including interstitial pneumonia, associated with immune checkpoint inhibitors.
These findings carry substantial significance as they offer a simple and effective means to enhance the efficacy of ICB while minimizing its associated side effects. By targeting tumor-positive lymph nodes with ICIs, the anti-tumor response can be amplified, and the occurrence of irAEs can be reduced, leading to improved outcomes for cancer patients. Moving forward, Tohoku University plans to conduct further investigations and clinical trials to validate the efficacy of lymphatic targeted approaches in humans.